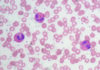
Ουδετεροπενίες στα παιδιά

Τεχνικές, συμπεριλαμβανομένης της μητρικής υστερεκτομής , της ελάχιστης εμβρυοσκoπικής πρόσβασης, και της διαδερμικής εμβρυϊκής πρόσβασης.
ΓΕΝΙΚΕΣ ΑΡΧΕΣ
Η μητέρα δεν έχει τίποτα να κερδίσει από την άποψη των οφελών υγείας από οποιαδήποτε εμβρυϊκή επέμβαση, όμως διατρέχει έναν σημαντικό κίνδυνο για νοσηρότητα και ακόμη και την πιθανή θνησιμότητα με μια εμβρυϊκή χειρουργική επέμβαση.
ΕΜΒΡΥΪΚΗ ΠΡΟΣΒΑΣΗ
Υπάρχουν τρεις γενικές μέθοδοι για την πρόσβαση στο έμβρυο:
(1) παρακέντηση με την καθοδήγηση υπερήχου
(2) εμβρυοσκόπηση και
(3) ανοικτή υστεροτομή
Η μητέρα τοποθετείται συνήθως ύπτια ή αριστερά πλάγια για να ελαχιστοποιήσει τη πίεση της κάτω κοίλης φλέβας από την έγγυο μήτρα. Η μητρική αναισθησία μπορεί να είναι είτε νωτιαία είτε γενική, ανάλογα με τη φύση και διάρκεια της επέμβασης. Επιπλέον, η εμβρυϊκή αναισθησία απαιτείται. Μια ενδομυϊκή έγχυση μιας οπιούχου ουσίας και ένας νευρομυϊκός αποκλειστής χρησιμοποιείται συνήθως.
Είναι σημαντικό να προσδιοριστεί ένα «παράθυρο» μέσα στη μήτρα που είναι μακριά από τον πλακούντα για να μειωθεί ο κίνδυνος μητρικής αιμορραγίας, αποκόλλησης πλακούντα ,και εμβρυϊκής νοσηρότητας.
Οι ανοικτές εμβρυϊκές επεμβάσεις απαιτούν γενική αναισθησία.
ΑΝΩΜΑΛΙΕΣ ΥΠΟΚΕΙΜΕΝΕΣ ΣΕ ΕΜΒΡΥΪΚΗ ΧΕΙΡΟΥΡΓΙΚΗ ΕΠΈΜΒΑΣΗ
Συγγενής διαφραγματοκήλη
Η επέμβαση μπορεί να επιτρέψει την εμβρυική αύξηση πνευμόνων, πνευμονική λειτουργία, και αύξηση της επιβίωσης.
Το τελευταίο τρίμηνο, με ένα ενδοθωρακικό μπαλόνι στη τραχεία επιτρέπει στον πνεύμονα να αυξηθεί και να αναπτυχθεί αρκετά για να επιτρέψει την επιβίωση. Αφαιρείται λίγο πριν τον τοκετό.
Όγκοι
Ευτυχώς, οι εμβρυϊκοί όγκοι είναι σπάνιοι. Διαγνωσθέντες όγκοι είναι συγγενής βρογχοπνευμονική δυσπλασία (CPAMs) και το ιεροκοκκυγικό τεράτωμα(SCT).
Συγγενής βρογχοπνευμονική δυσπλασία (CPAMs)
Μόλις φθάσει το έμβρυο σε βιώσιμη κυητική ηλικία, ο πρόωρος τοκετός πρέπει να εξεταστεί.
Εμβρυϊκή θωρακοτομή μετά από μητρική υστεροτομή.
Ο λοβός με βρογχοπνευμονική δυσπλασία προσδιορίζεται και εξωτερικεύεται μέσω της τομής.
Ιεροκοκκυγικό τεράτωμα SCTs
Το ιεροκοκκυγικό τεράτωμα είναι ένας σπάνιος όγκος που είναι διαγνώσιμος ήδη από την εμβρυική ηλικία.
Το SCTs μπορεί να αυξηθεί σε ένα τεράστιο μέγεθος σε σχέση με το έμβρυο και μπορεί να προκαλέσει υψηλής παροχής καρδιακή ανεπάρκεια και ύδρωπα. Σπάνια, οι όγκοι μπορούν να αιμορραγήσουν εσωτερικά ή εξωτερικά, με συνέπεια την εμβρυϊκή αναιμία και την υπογκαιμία.
Άλλα πιθανά προβλήματα με ένα έμβρυο με μεγάλο SCT είναι η δυστοκία.
Η πιο κοινή προσέγγιση για την εμβρυϊκή επέμβαση για ένα SCT είναι η μητρική υστεροτομή με εκτομή του όγκου.
Ανωμαλίες των δίδυμων κυήσεων
Σύνδρομο Δίδυμο-δίδυμης μετάγγισης (TTTS)
Το TTTS είναι πιο πολύ κοινή επιπλοκή (10%) των μονοχοριονικών διδύμων.
Ως αποτέλεσμα της μετάγγισης του αίματος, το χορηγών δίδυμο παρουσιάζει χαμηλή ροή με κατάληξη ισχαιμία στον εγκέφαλο και νεφρούς. Αντιθέτως, το λαμβάνων δίδυμο έχει υπερφόρτωση και μπορεί να αναπτυχθεί συμφορητική καρδιακή ανεπάρκεια και ύδρωψ.
Η συνηθέστερα χρησιμοποιημένη προσέγγιση είναι αμνιοαπορρόφηση στον πολυυδραμνιακό σάκο.
Ενδομήτρια διατομή με laser αναστομωτικών αγγείων.
Μηνιγγομυελοκήλη η δισχιδής ράχη MMC
Χαρακτηρίζεται από έναν ανοικτό νευρικό σωλήνα.
MMC μπορεί να εμφανιστεί οπουδήποτε κατά μήκος της σπονδυλικής στήλης, αλλά συνηθέστερα εμφανίζεται οσφυϊκά ή αυχενικά. Αποτέλεσμα τα νευρολογικά ελλείμματα και σωματοαισθητηριακές ανωμαλίες.
Επιπλέον, η αυτόνομη λειτουργία είναι επίσης συνήθως διαταραγμένη με μια ανικανότητα να ελεγχθεί η κύστη ή η λειτουργία εντέρων.
Η τυποποιημένη τρέχουσα θεραπεία για MMC είναι μεταγεννητική αποκατάσταση του νωτιαίου ελλείμματος.
Στένωση αορτικής βαλβίδας
Βαλβιδοτομή ενδομήτρια
Σε υποκριτικό κώλυμα κύστης
Παροχέτευση κύστης στην αμνιακή κοιλότητα
Σε γαστρόσχιση
Περιοδική ανταλλαγή αμνιακού υγρού
ΓΟΝΙΔΙΑΚΗ ΘΕΡΑΠΕΙΑ
Η θεραπεία γονιδίων είναι αυτήν την περίοδο πειραματική.
Περίληψη
Η εμβρυϊκή χειρουργική επέμβαση έχει προχωρήσει από ένα ερευνητικό επίπεδο θεραπείας σε έναν αποδεκτό τρόπο θεραπείας για επιλεγμένες εμβρυϊκές ασθένειες.
Δεδομένου ότι οι τεχνικές ελάχιστης πρόσβασης βελτιώνονται, και οι μητρικοί κίνδυνοι μειώνονται περαιτέρω, οι ενδείξεις για εμβρυϊκή επέμβαση μπορεί να συνεχίσουν να διευρύνονται.
Η μητρική ασφάλεια πρέπει να παραμείνει και ο κίνδυνος για τη μητέρα πρέπει να είναι ελαχιστοποιημένος πάντα.
Η γονιδιακή θεραπεία μπορεί να είναι εφαρμόσιμη σε
Αιματολογικά νοσήματα
- α-θαλασσαιμία
- Αναιμία Fanconi
- Χρόνια κοκκιωμάτωση
- Αιμορροφιλία Α
Ανοσοποιητικά νοσήματα
- Σύνδρομο (SCID) ανεπάρκειας αντισωμάτων
- Σύνδρομο Wiskott-Aldrich
Μεταβολικά νοσήματα
- Ασθένεια Wolman
- Τύπος ΙΙ ασθένεια Gaucher
- Ασθένεια Pompe
- Κυστική ίνωση
Νευρολογικά νοσήματα
-
- Σύνδρομο Lesch-Nyhan
- Ασθένεια Tay-Sachs
- Ασθένεια Sandhoff
- Ασθένεια Niemann
- Λευκοδυστροφια
- Γενικευμένη γαγγλιοσίδωση
- Ασθένεια Leigh

Δρ. Μιχάλης Παγώνης MD
Παιδοχειρουργός
Παιδοχειρουργικό-Παιδοουρολογικό ιατρείο
99612878
michalispagonis@yahoo.com
Συνέσειο ιατρικό κέντρο
Τηλ. 24641111
Νοσοκομείο
Τίμιος Σταυρός
Λάρνακα